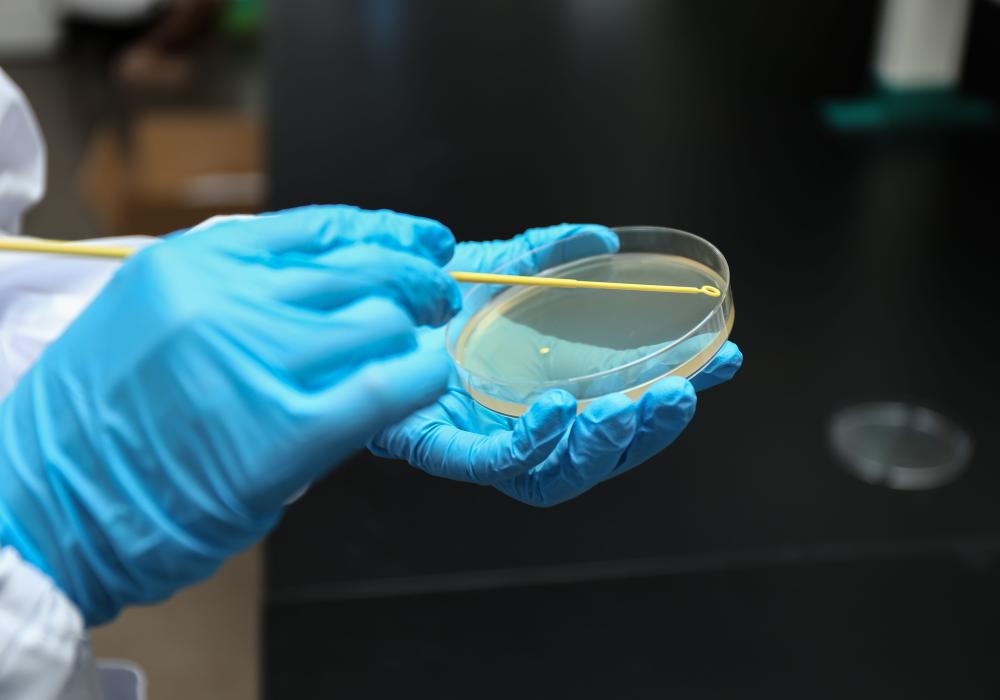

NEST Bacterial Culture Petri Dishes
$0.14
These non-treated polystyrene plates are transparent and DNase/RNase-Free. The bottom has a ridge allowing for easy handling and stacking. The plate has three vents for gas exchange. Suitable for bacterial culture.
Description
These non-treated polystyrene plates are transparent and DNase/RNase-Free. The bottom has a ridge allowing for easy handling and stacking. The plate has three vents for gas exchange. Suitable for bacterial culture.
Features:
- High clarity polystyrene
- Flat transparent surface
- Numeric mark on the bottom for easy identification
- PA/PE packaging
- Vent for gas exchange
- Stackable for easy storage and handling
- Non-pyrogenic
- Sterilized by E-Beam, SAL=10-6